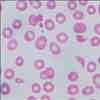
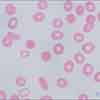
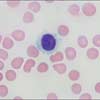
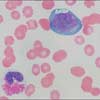

A 56-year-old woman presents for a routine examination. She has been healthy, and results of previous examinations have been normal.
Case 1:Postmenopausal Woman With Petechial Rash
A 56-year-old woman presents for a routine examination. She has been healthy, and results of previous examinations have been normal. She does not smoke or drink alcohol, and she has no family history of significant medical problems. She has had 3 normal pregnancies and uneventful deliveries. The patient has never received transfusions of any blood products. There is no history of thrombophilia.
A rash on her lower extremities appears to be petechial. The rash is not palpable, and there are no ecchymoses. Her blood pressure is 126/78 mm Hg. There is no evidence of splenomegaly, either by percussion (Castelli sign) or palpation, nor is there evidence of adenopathy or liver disease. Results of routine laboratory and screening tests (mammography, fecal occult blood testing) are normal (including hemoglobin level, white blood cell count, differential, international normalized ratio, and partial thromboplastin time) except for a platelet count of 50,000/µL. The patient denies any bleeding.
Which of the following statements is FALSE?
A. A thorough medication history that includes both prescription and over-the-counter medications is critical to determine whether the patient has medication-induced thrombocytopenia.
B. HIV infection may present initially as an isolated thrombocytopenia.
C. Results of testing for the lupus anticoagulant will probably be negative in this woman.
D. A peripheral smear examination will not help in her evaluation.
Answer: D is false.
Because this patient's platelet count is decreased without an apparent change in either red or white blood cells, the "VIC G. SAID" portion of the mnemonic (see Table, page 107) is most likely appropriate for determining the cause of her thrombocytopenia (although this requires confirmation by the peripheral smear).
It is essential to obtain a detailed medication history as well as a sexual history. The former shows that she was not taking any medications, either prescription or over-the-counter. HIV might have been the cause of her thrombocytopenia if appropriate risk factors were present.1 However, she is married and monogamous, and she has no history of needle or illicit drug exposures.
She does not appear to have any symptoms of systemic lupus erythematosus (eg, arthritis, characteristic rash, serositis) or of any other vasculitis that might be associated with immune-mediated thrombocytopenia. Her rash is not palpable; thus, it is not palpable purpura, which results from vasculitis.She has no history to support post-transfusion purpura.
The patient has no complaints referable to a recent viral infection (eg, exposure, rash, jaundice). The absence of thrombosis and spontaneous abortions makes the presence of lupus anticoagulant or other manifestations of the antiphospholipid antibody syndrome unlikely.
Thus, there is no compelling evidence for viral, splenic, vasculitic, infectious, or drug causes of her thrombocytopenia. Previous platelet counts and history have been unremarkable, so a congenital cause is unlikely. Because she is postmenopausal, pregnancy is not a possible cause. Thus, most of the diagnostic possibilities enumerated by the "VIC G. SAID" portion of the mnemonic can be ruled out. This leaves an immune- mediated process as the most likely diagnosis.
A peripheral smear is important at this stage to ensure that only one blood cell line (platelets) is dis- turbed. If schistocytes or other abnormal cells were present, diagnostic possibilities, as well as the scope of the workup, would change. For instance, thrombocytopenia in the presence of a mature lymphocytosis might represent autoimmune thrombocytopenia associated with chronic lymphocytic leukemia (see Case 4). However, her peripheral smear results are normal except for the obvious decrease in platelet number and the presence of some (one third of those visible) "younger"--that is, larger--platelets. Thus, this patient's thrombocytopenia is most likely idiopathic.
Often assumed to be only a disease of younger women, idiopathic thrombocytopenic purpura (ITP) has a median age at diagnosis of 56.4 years. It occurs 1.7 times more frequently in women than in men.2
What is the next step in the workup?
A. A bone marrow examination.
B. Antiphospholipid antibody testing.
C. No further workup is required.
D. Screening for anti-platelet antibodies.
Answer: C is correct.
A practice guideline for ITP developed by the American College of Hematology states, "The diagnosis of ITP is based principally on the history, physical examination, complete blood count, and examination of the peripheral smear, which should exclude other causes of thrombocytopenia. ITP is the predominant cause of immune-mediated thrombocytopenia."3 Thus, no additional tests (eg, imaging studies, tests for lupus anticoagulant and platelet-specific antibodies) are necessary for this patient.
Bone marrow examination is an occasional exception to this guideline. While the study should not be routinely included in the workup for an isolated thrombocytopenia, it should be included if there are signs of a myeloproliferative disorder (other cell lines are disturbed or peripheral smear is abnormal) or if the patient is older than 60 years.
A review of the treatment of ITP is beyond the scope of this discussion. Stasi and Provan2 recently proposed an evidence-based management strategy.
Immune-mediated thrombocytopenia in women of child-bearing age. If this woman were younger, pregnancy would have to be considered as a potential trigger for her immune-mediated thrombocytopenia.3,4 Diagnosing ITP is more difficult in women who are pregnant because of the similarities between ITP and gestational thrombocytopenia, the most common cause of thrombocytopenia during pregnancy. Other pregnancy-related causes of thrombocytopenia are the HELLP syndrome (Hemolysis, Elevated Liver enzyme levels, and Low Platelet count) and preeclampsia. However, in both these entities, thrombocytopenia is accompanied by hemolytic anemia. The presence of hypertension, elevated liver enzyme levels, and schistocytes in the HELLP syndrome and preeclampsia usually makes differentiating them from ITP or gestational thrombocytopenia fairly easy.
It can be more difficult to distinguish between ITP and gestational thrombocytopenia; however, some specific features of the 2 entities can help. Women who have gestational thrombocytopenia tend to have higher platelet counts (above 50,000/µL) than do those who have ITP, do not have a past history of thrombocytopenia (except during previous pregnancies), and exhibit low platelet counts later during gestation. Also, gestational thrombocytopenia does not cause fetal thrombocytopenia as ITP can, and it resolves promptly after delivery; ITP often does not. A study by Samuels and colleagues5 offers tips on distinguishing ITP from other causes of thrombocytopenia during pregnancy.
Case 2:
Drop in Platelet Count After Surgery
A 66-year-old man undergoes resection of a squamous cell carcinoma of the pharynx. Shortly thereafter, he complains of pain in his left arm, which has become edematous. Doppler ultrasonography confirms a thrombus in the left subclavian, axillary, brachial, and basilic veins. Low molecular weight heparin therapy is initiated. (He also received heparin on admission to the hospital, before surgery.) Warfarin is added the following day. Mottling develops over the skin of his left hand. A complete blood cell (CBC) count reveals a platelet count of 78,000/µL, a normal hemoglobin level, and a normal white blood cell count. Electrolyte levels are also normal. (The day before surgery, his platelet count was 225,000/µL.)
The next day, the patient's hand turns blue and edema increases. Sensation to touch over the involved area is decreased. Arterial pulses are present. Later that day, the platelet count falls to 20,000/µL. Twenty-four hours later, hemorrhagic bullae develop on his hand, with necrosis of the skin over the distal phalanges. Heparin-induced thrombocytopenia (HIT) and thrombosis are suspected.
Which of the following statements is FALSE?
A. The diagnosis of HIT is a clinical diagnosis.
B. HIT results from an immunologic drug reaction.
C. The incidence of HIT in the ICU setting is less than 1%.
D. The treatment of HIT is cessation of all heparin products; nothing else is required.
Answer: D is false.
This patient's CBC count is normal except for a low platelet count. Because he has an isolated thrombocytopenia, the "VIC G. SAID" portion of the mnemonic is most useful in determining the cause (see page 107).
The timing of the drop in the patient's platelet count is critical to making a clinical diagnosis of HIT. The decline from 225,000 to 78,000/µL occurred about 6 days after the initiation of heparin, as did the appearance of evidence of deep venous thrombosis.
The diagnosis of HIT in its early stages is clinical. Because HIT can cause catastrophic events, including venous limb gangrene and arterial thrombosis, it is important to recognize and act on it quickly. Suspect HIT under the following conditions:
When HIT is suspected based on the history and physical findings, stop all heparin products immediately and start another anticoagulant. In addition, further testing to confirm the diagnosis may be ordered. An enzyme-linked immunosorbent assay--an antigen-based test--is highly sensitive but lacks specificity.7 Another test, the serotonin release assay (SRA), is a functional assay with moderate sensitivity and high specificity. However, the SRA has a long turnaround time.8 In a prospective study, the incidence of HIT in the ICU was about 0.39%, based on clinical criteria and positive SRA results.9
Heparin-induced thrombocytopenia results from the formation of antibodies to the heparin-platelet factor 4 complex; these antibodies initiate platelet activation. The antibodies, which belong to the IgG class, typically target both high and low molecular weight heparin.10 Thus, low molecular weight heparin can cause HIT, although it is implicated less often than unfractionated heparin.11
The treatment of HIT does not end with discontinuation of all heparin products. Although it is crucial to diagnose HIT early and to stop heparin promptly, additional therapy is required. Conservative management of HIT (ie, stopping heparin only) is associated with an incidence of thrombosis as high as 50% at 1 month.12
Definitive treatment requires both discontinuation of heparin and the administration of a direct thrombin inhibitor such as argatroban or lepirudin. Both these agents are FDA-approved for the treatment of HIT. Argatroban and lepirudin act against soluble as well as clot-bound thrombin. Argatroban must be given orally, undergoes hepatic elimination, and can increase the international normalized ratio (INR). Lepirudin is administered subcutaneously, is not metabolized in the liver, and does not affect the INR. Keep in mind, however, that there is no antidote that can reverse the anticoagulant effects of lepirudin. Furthermore, the dosage of this agent needs to be adjusted in patients with any degree of renal failure.
This patient underwent amputation of his hand and was discharged from the hospital with a prescription for argatroban. No further thrombotic events occurred.
Case 3:
Older Man With Acute Febrile Illness
Figure 1
A 66-year-old man presents with fever (temperature of 38.3°C [101°F]) and an abnormal complete blood cell (CBC) count after feeling ill for 36 hours. He denies exposure to any sick persons as well as recent travel. He has Alzheimer disease, which makes it difficult for him to answer some of your questions. He has no other significant medical history. His blood pressure is 110/82 mm Hg; heart rate, 109 beats per minute and regular; respiration rate, 22 breaths per minute; and oxygen saturation by oximeter, 90%. Hemoglobin level is 10.2 g/dL; white blood cell count, 12,000/µL; and platelet count, 33,000/µL. His blood urea nitrogen level (33 mg/dL) and creatinine level (2.6 mg/dL) indicate azotemia.
Because he has both anemia and thrombocytopenia, the "TED" portion of the mnemonic would seem most relevant. However, before applying the mnemonic, you need to confirm that the patient's thrombocytopenia and anemia are both caused by the same underlying disease process. To determine this, you examine the peripheral smear (Figure 1).
Which of the following are correct?
A. The patient could have hemolytic uremic syndrome (HUS).
B. The peripheral smear will not be as helpful in this setting as it is in the setting of thrombocytopenia without anemia.
C. The key to differentiating disseminated intravascular coagulation (DIC) from a thrombotic microangiopathy (such as HUS or thrombotic thrombocytopenic purpura [TTP]) is demonstration of the "consumption" of clotting factors (as determined by the presence of D-dimer and other markers).
D. The correct identification of red cell morphology, especially the differentiation of spherocytes and schistocytes, can establish whether the primary disease process in this man has an immune or a mechanical cause.
Answer: A, C, and D are correct.
Two clues from the peripheral smear help narrow the differential diagnosis considerably. First, careful scanning of the smear shows that the white cell morphology is normal; this finding confirms that the cause of the patient's thrombocytopenia is included in the "TED" portion of the mnemonic (see Table, page 107). (Specific white cell anomalies [blasts, for example] would suggest that the last portion of the mnemonic [SAMMM] should be applied.) Second, the morphology of red cells seen on the smear--schistocytes (see Figure 1)--is critical to establishing hemolysis as the cause of the patient's anemia as well as to determining the mechanism of the hemolysis (mechanical). (The presence of spherocytes would have indicated an immune hemolysis.) In addition to the foregoing, no parameters suggest an alternate cause for his anemia, such as anisocytosis/microcytosis (iron deficiency) or macrocytosis (vitamin B12 deficiency).
The absence of spherocytes rules out an immune cause for the hemolysis (Evans syndrome). Next, it must be determined whether a thrombotic microangiopathy (the "T" in the mnemonic) or DIC (the "D" in the mnemonic) is the diagnosis. Low platelet counts, anemia, varying degrees of renal insufficiency, fever, and the presence of schistocytes characterize both entities. However, DIC, unlike either TTP or HUS, tends to "consume" clotting factors; this may eventually lead to a prolongation of the international normalized ratio (INR), partial thromboplastin time (PTT), and thrombin time. Unfortunately, DIC results in an abnormal INR or PTT only about 50% of the time.13 Other tests, such as the D-dimer assay and measurements of prothrombin fragment 1+2 and fibrinopeptide A, are more reliable ways to differentiate DIC from a thrombotic microangiopathy.13
Results of this patient's D-dimer assay were positive, his fibrinopeptide A level was elevated, and he had a prolonged INR and PTT and decreased fibrinogen level. These findings, together with his peripheral smear, were consistent with DIC rather than HUS or TTP. On further examination, he was found to have a prostatic mass and an elevated prostate-specific antigen level. Prostate cancer was diagnosed as the cause of the DIC. His disease was far advanced, with metastases at multiple sites, so palliative care was provided. He died 10 days later.
Case 4:
Older Woman With Fatigue and Mucosal Bleeding
A 66-year-old woman complains of fatigue and mucosal bleeding. She was well until 4 months ago, at which time increasing fatigue led her to shorten her evening walks from 2 miles to about a quarter of a mile. During this same period, her appetite diminished and she lost 8 lb. This past week, her gums bled after vigorous brushing.
She has essential hypertension, for which she takes an angiotensin-converting enzyme inhibitor, and she had a hernia repaired 10 years earlier. Eight months ago, her blood pressure was 132/88 mm Hg, her low-density lipoprotein cholesterol level was 140 mg/dL, and a complete blood cell (CBC) count was normal. Results of a recent screening colonoscopy were negative.
Examination reveals petechiae on both ankles, adenopathy (firm nodes 1 to 2 cm in diameter) in the anterior cervical and femoral chains, moderate splenomegaly, and an easily palpable liver (length by percussion, about 16 cm). Blood pressure is 146/98 mm Hg. Results of the rest of the examination are unremarkable.
Figure 2
Hemoglobin level is 10.2 g/dL. A white blood cell count is 23,000/µL, with 75% mature lymphocytes; platelet count is 80,000/µL. The peripheral smear shows sphere-shaped red cells, monotonous mature lymphocytes, and some lymphocytes that are "smudged" (ie, that show a loss of distinct cell and nuclear membrane margins) (Figure 2). Results of a Coombs test are positive, consistent with an immune origin for the spherocytes. An absolute reticulocyte count (uncorrected reticulocyte count multiplied by the red blood cell count) is elevated at 130,000/µL; thissuggests that the patient's anemia is secondary to a hemolytic process. Also consistent with hemolysis, her lactate dehydrogenase level is 3 times normal.
Which of the following statements are FALSE?
A. If the red cell morphology were characterized by teardrop shapes, the cause of the thrombocytopenia could be myelofibrosis or myelophthisis.
B. Since all 3 cell lines are affected, quinine ingestion is not a likely cause of the thrombocytopenia.
C. The anemia is secondary to marrow involvement associated with chronic lymphocytic leukemia (CLL).
D. This patient's most likely diagnosis is primary myelodysplasia.
Answer: C and D are false.
The key diagnostic features of this patient's presentation are:
Because all 3 blood cell lines are affected, the "SAMMM" portion of the mnemonic is most helpful in establishing a diagnosis. Results of flow cytometry and a bone marrow examination are consistent with B-cell CLL.
The morphology of this patient's white and red blood cells plays a key role in establishing the diagnosis; other morphologies would probably have led to different diagnoses. To illustrate how important the peripheral smear can be in the correct diagnosis of thrombocytopenia that falls in the "SAMMM" portion of the mnemonic, consider how other smears, accompanied by clinical and laboratory findings similar to this woman's, would be interpreted.
Figure 3
Figure 4
If the patient's peripheral smear had shown hairy white cells (Figure 3), the disease process responsible for her thrombocytopenia, anemia, and leukocytosis would probably have been hairy cell leukemia. If the smear had shown blasts of the myelocytic line (Figure 4), the diagnosis would most likely have been acute myelocytic leukemia. If teardrop-shaped and nucleated red blood cells, rather than spherocytes, had been present, marrow infiltration by leukemic cells would most likely have led to her anemia and thrombocytopenia.
If the disturbance in the white cell line had been a decrease in number rather than an increase, myelodysplasia or myelofibrosis might have been responsible. Consider primary myelodysplasia when pancytopenia is accompanied by mild to moderate red cell macrocytosis (mean corpuscular volume, 100 to 110 fL, with red cell morphology otherwise typically unremarkable).13 Secondary myelodysplasia can occur in response to vitamin B12 or folic acid deficiency or as a result of ingestion of alcohol or other drugs, such as methotrexate, that interfere with cell maturation in the bone marrow. Here, too, the peripheral smear can help with diagnosis: hypersegmented neutrophils are indicators of vitamin B12 deficiency.
Case 5:
Young Woman With Pharyngitis
A 23-year-old woman presents with malaise of 4 days' duration that now is accompanied by pharyngitis and swelling in the area of her anterior cervical lymph nodes. Examination reveals tender lymph nodes 2 cm in diameter and mild splenomegaly on percussion. The patient delivered a healthy infant 6 months earlier; however, she was anemic throughout her pregnancy. She took iron supplements for a few weeks but discontinued them because of constipation. She has a history of menorrhagia.
A complete blood cell count shows a hemoglobin level of 10.9 g/dL, white blood cell count of 13,000/µL with an increased percentage of "atypical" lymphocytes, and platelet count of 99,000/µL. The absolute reticulocyte count is low (30,000/µL). The mean corpuscular volume is 86 fL, and the red blood cell volume distribution width (RDW) is 19 (upper limit of normal, 13). A peripheral smear shows hypochromia and atypical lymphocytes; morphology of the remainder of the white cells in the differential is normal.
Which of the following is true?
A. The patient has isolated thrombocytopenia.
B. Her thrombocytopenia and anemia result from a common disease process, but her white blood cell abnormalities have a different cause.
C. The same disease process has produced disturbances in all 3 blood cell lines.
D. Her history of menorrhagia is of no diagnostic significance.
Answer: A is true.
This patient has abnormalities in all 3 of her blood cell lines. However, to make productive use of the mnemonic in this case, one must pay careful attention to the patient's history, red cell indices, and peripheral smear findings.
The history, indices, and peripheral smear help rule out the possibility of a disease process included in either the "TED" or "SAMMM" portion of the mnemonic. Her white blood cell abnormalities (atypical lymphocytes) are not consistent with any of the entities included in the "SAMMM" portion of the mnemonic that are characterized by leukocytosis; no hypersegmented neutrophils or blast forms are evident. Moreover, the smear does not show red cells affected by a hemolytic disease (schistocytes or spherocytes), such as the entities in the "TED" portion of the mnemonic. Instead, her anemia is characterized by anisocytosis (as demonstrated by the increased RDW) and hypochromia. These findings suggest iron deficiency. Her history of menorrhagia, her anemia during pregnancy, and her past (unsuccessful) treatment with iron supplementation are also consistent with iron deficiency as the cause of her anemia.
Iron deficiency alters red blood cells consistently.12 First, RDW/anisocytosis increases; anemia occurs next. Only later does microcytosis supervene. Only about a third of iron-deficient persons have small red blood cells. This woman had a ferritin level of 18 ng/mL. She had iron deficiency anemia, and her thrombocytopenia was the result of another, unrelated acute pathology that the "VIC G. SAID" portion of the mnemonic would be most helpful in diagnosing.
Her white cell abnormality was an increase in atypical lymphocytes, as is commonly seen in infectious mononucleosis caused by Epstein-Barr virus. Further workup was consistent with this diagnosis. Thus, her thrombocytopenia was viral in origin. (Note that although the patient's spleen was enlarged, the underlying infectious disease was the primary cause of her thrombocytopenia.)
REFERENCES:
1.
Bettaieb A, Fromont P, Louche F, et al. Presence of cross-reacting antibodybetween HIV and platelet glycoprotein in HIV-related immune thrombocytopenicpurpura. Blood. 1992;80:162-169.
2.
Stasi R, Provan D. Management of idiopathic thrombocytopenic purpura inadults. Mayo Clin Proc. 2004;79:504-522.
3.
George JN, Woolf SH, Raskob GE, et al. Idiopathic thrombocytopenic purpura:a practice guideline developed by explicit methods for the American Societyof Hematology. Blood. 1996;88:3-40.
4.
McCrae KR, Samuels P, Schreiber AD. Pregnancy-associated thrombocytopenia:pathogenesis and management. Blood. 1992;80:2697-2714.
5.
Samuels P, Bussel JB, Braitman LE, et al. Estimation of the risk of thrombocytopeniain the offspring of pregnant women with presumed immune thrombocytopenicpurpura. N Engl J Med. 1990;323:229-235.
6.
Warkentin TE, Chong BH, Greinacher A. Heparin-induced thrombocytopenia:towards consensus. Thromb Haemost. 1998;79:1-7.
7.
Zwicker JI, Uhl L, Huang WY, et al. Thrombosis and ELISA optical densityvalues in hospitalized patients with heparin-induced thrombocytopenia. J ThrombHaemost. 2004;2:2133-2137.
8.
Spinler S, Dager W. Overview of heparin-induced thrombocytopenia. Am JHealth-Syst Pharm. 2003;60(20):S5-S11.
9.
Verma AK, Levine M, Shalansky SJ, et al. Frequency of heparin-inducedthrombocytopenia in critical care patients. Pharmacotherapy. 2003;23:745-753.
10.
Walenga JM, Jeske WP, Prechel MM, Bakhos M. Newer insights on themechanism of heparin-induced thrombocytopenia. Semin Thromb Hemost. 2004;30:57-67.
11.
Walenga JM, Jeske WP, Prechel MM, et al. Decreased prevalence of heparin-induced thrombocytopenia with low-molecular-weight heparin and relateddrugs. Semin Thromb Hemost. 2004;30:69-80.
12.
Bergin J. Anemia: a strategy for the workup. Consultant. 2002;42:869-882.
13.
Bick RL. Disseminated intravascular coagulation: current concepts of etiology,pathophysiology, diagnosis, and treatment. Hematol Oncol Clin North Am.2003;17:149-176.